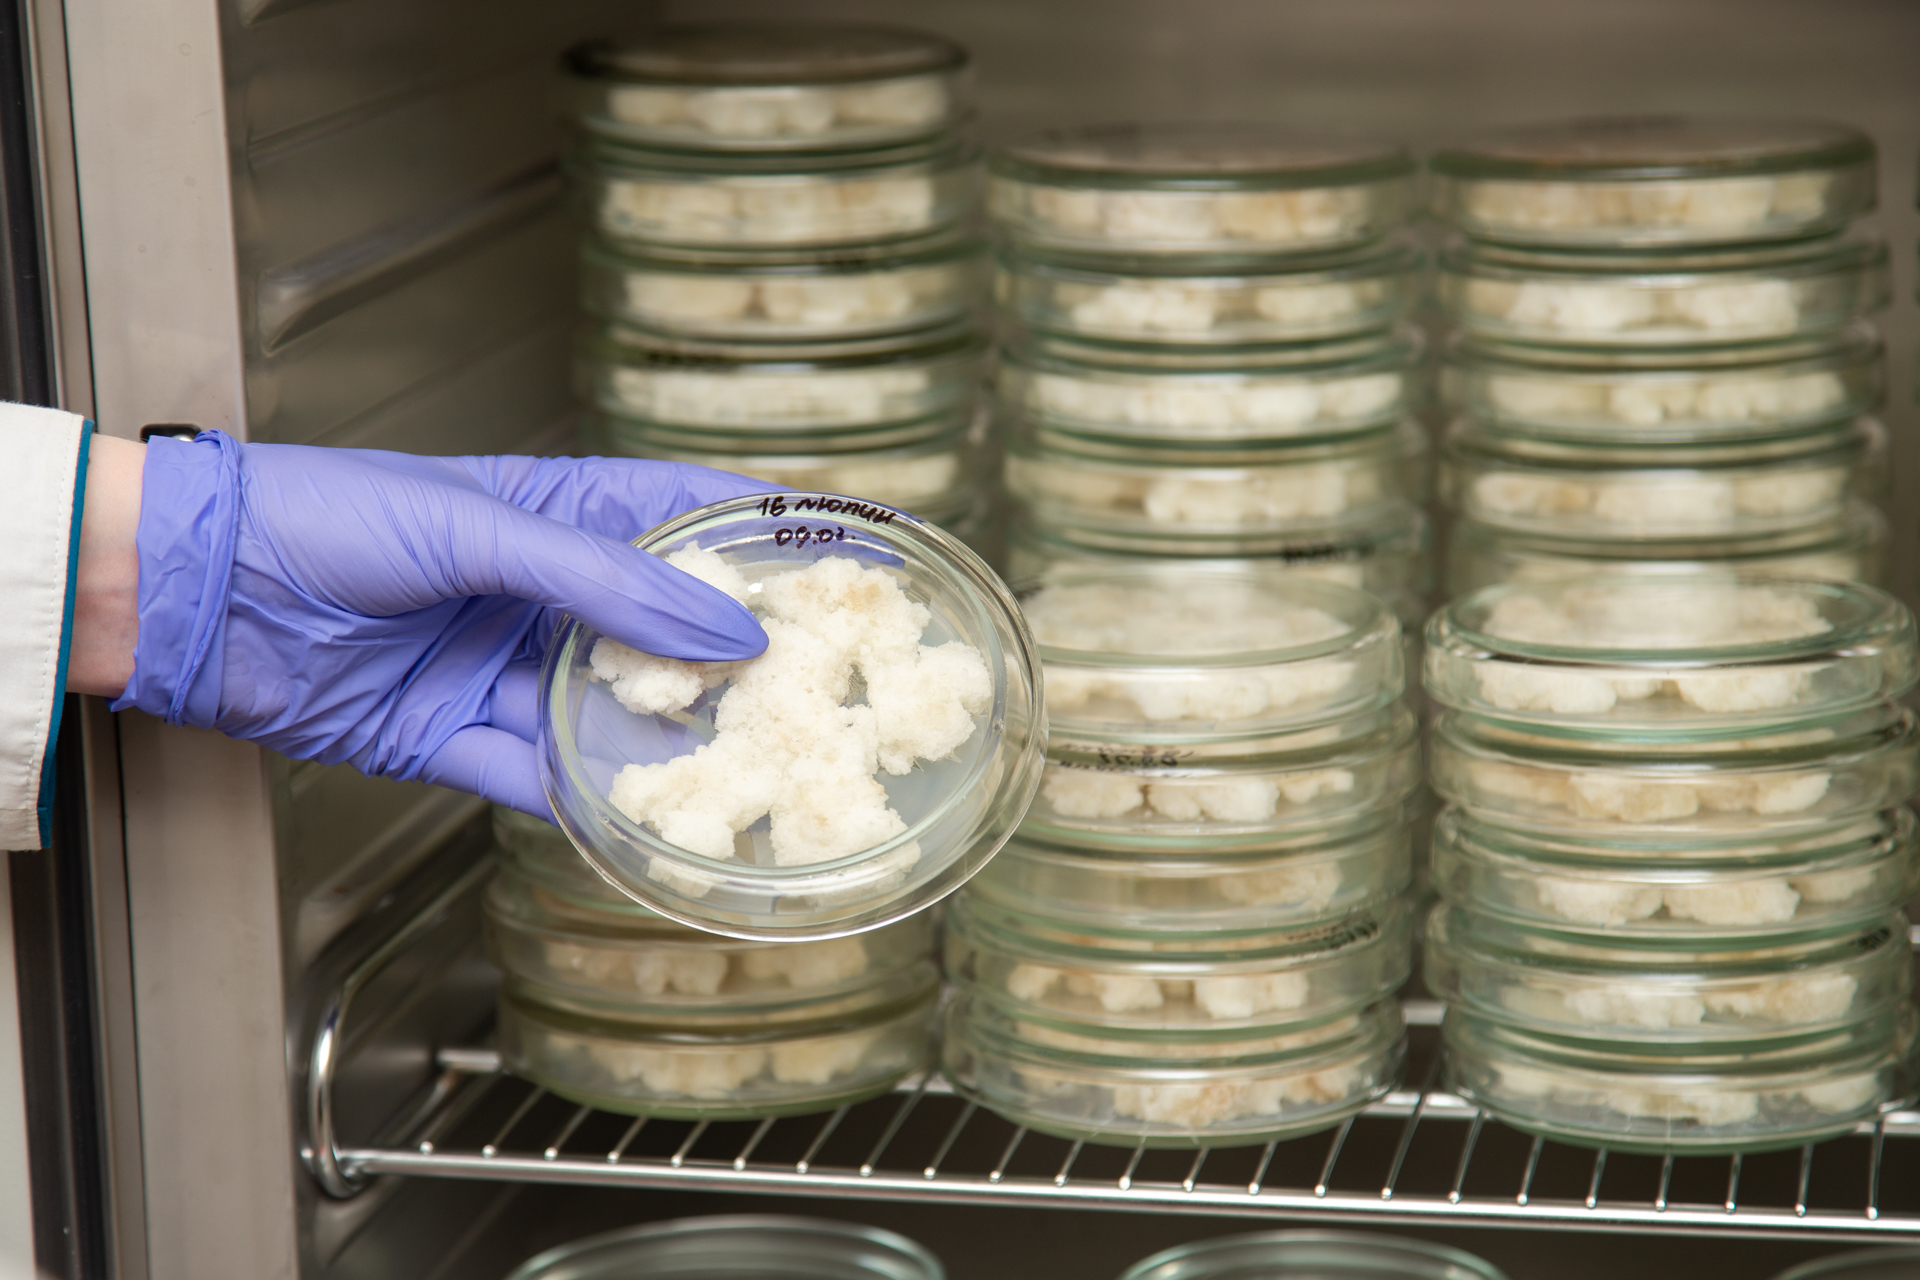

Напомним, что одной из ключевых составляющих программы развития Вятского государственного университета является стратегический проект «Технологии здоровья». Стратпроект включает в себя несколько направлений, в числе которых здоровое питание.
Проректор по науке и инновациям ВятГУ Сергей Литвинец рассказал:
Для того, чтобы создать продукты, которые будут удовлетворять все потребности человека, мы занимаемся технологиями пищевого поведения.
Благодаря программе «Приоритет-2030» открыта лаборатория пищевой 3D-печати. Программа позволила нам приобрести новое оборудование, дать возможность молодым исследователям заниматься любимым делом и получать прикладные результаты.
Среди таких людей аспирантка Института биологии и биотехнологии ВятГУ Елена Душина, активная участница команды стратпроекта «Технологии здоровья». Предваряя демонстрацию оборудования новой лаборатории, Елена осветила ряд вопросов, затрагиваемых при изучении пищевого поведения.
Одним из инструментов является трехмерная пищевая печать, с помощью которой мы создаем уникальные функциональные продукты питания, используя при этом растительное сырье, получаемое биотехнологическим путем,
- отметила Елена Душина.
Растительные клетки могут культивироваться на разных питательных средах. Выращивание клеток на жидкой питательной среде осуществляется в стеклянных колбах, помещенных в особый шейкер. Такое устройство обеспечивает постоянное перемешивание и необходимые температурные условия.
Клетки, культивируемые на твердой питательной среде, выращиваются в специальных термостатах – ими также оснащена новая лаборатория. В одном из ее помещений установлен ламинарный бокс: в нем исследователи осуществляют пересадку клеточных культур.
Выращенные растительные клетки являются главным ингредиентом биочернил, которые используются в трехмерной пищевой печати. 3D-принтер позволяет послойно воссоздавать уникальную модель на основе ранее построенной цифровой.
Технологии трехмерной пищевой печати дают возможность задать структуру, цвет, вкус. Таким образом, у нас получается продукт питания, по-настоящему полезный для организма человека,
- заключила Елена Душина.
Разработки команды стратпроекта «Технологии здоровья» уже вошли в федеральную повестку. Значимым достижением стало участие экспонатов (образцов пищевых чернил и образцов пищевых продуктов, полученных методом пищевой 3D-печати) в экспозиции Министерства науки и высшего образования, посвященной Десятилетию науки и технологий, на выставке-форуме «Россия». Такой успех стал возможен благодаря слаженной работе сильной команды в условиях современной исследовательской площадки, предоставляющей все возможности деятельности по востребованному направлению.
#ВятГУ #МыФормируемБудущее #Приоритет2030 #ТехнологииЗдоровья #ЗдоровоеПитание #НаучноИсследовательскаяПолитика #ИнфраструктурнаяПолитика #КампуснаяПолитика #ДесятилетиеНаукиИТехнологий


.jpg)
.jpg)
.jpg)